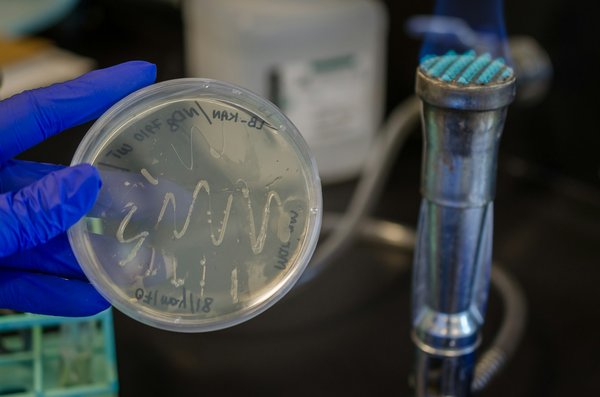
Trouvez votre boîte à colis chez Renz

Prenez le contrôle de la performance énergétique de vos bâtiments dès aujourd'hui
Prenez le contrôle de la performance énergétique de vos bâtiments dès aujourd'hui. Optimisez le confort et réduisez vos coûts grâce à des stratégies de gestion énergétique innovantes. Adoptez des tech...